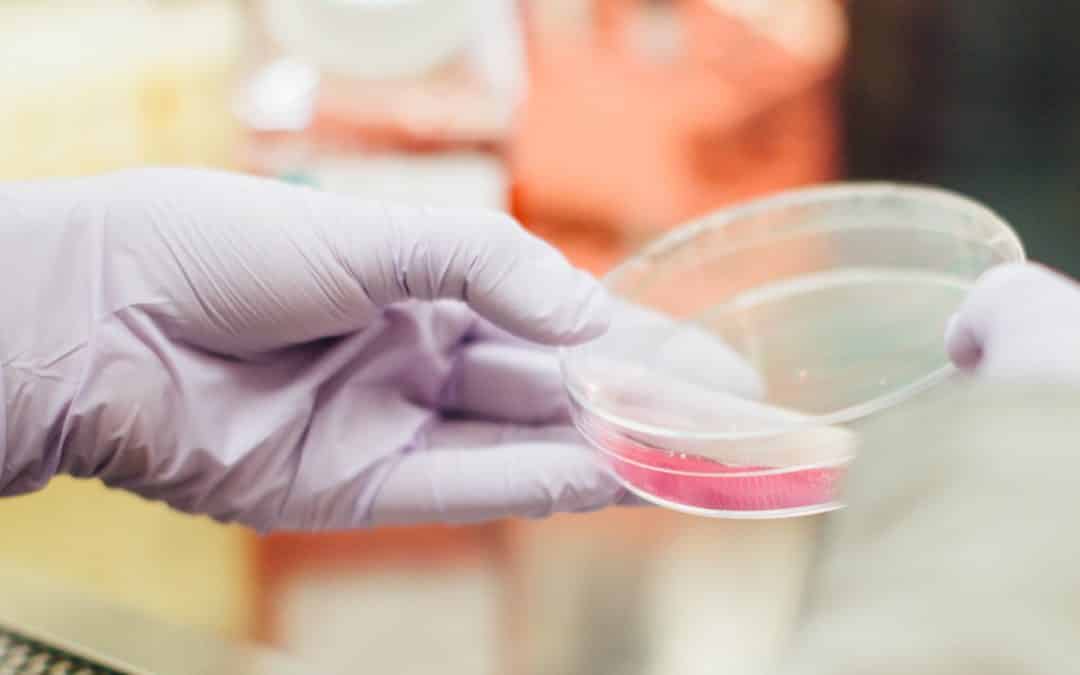
Time to fight AMR and improve transparency in the pharmaceutical industries

by European Public Health Alliance | Dec 14, 2020 | News Release, Statements
The first months and years of life lay the foundations for children’s physical, social and emotional development. Eurochild and the International Step by Step Association, in partnership with the European Public Health Alliance and the Roma Education Fund are...

by European Public Health Alliance | Dec 1, 2020 | News Release, Statements
The fight of the WHO clean air advocate mother, Rosamund Kissi-Debrah for clean air continues. Her daughter, Ella was only 9 years old when she succumbed to an asthma attack which has been linked to the illegal levels of air pollution in London. Rosamund has since...

by European Public Health Alliance | Oct 21, 2020 | News Release, Statements
Air pollution costs Europeans €1,276 per year – study Italy dominates top 10 cities for highest per capita costs 21 October 2020, Brussels – Air pollution costs the average European city resident €1,276 per year, according to the largest study of its kind....

by European Public Health Alliance | Sep 17, 2020 | News Release, Statements
18th September 2020, Brussels – High climate reduction targets set today can pave the way for a zero and low emission mobility tomorrow, the European Public Health Alliance (EPHA) highlighted in comments to mark the fifth year anniversary of the Dieselgate...

by European Public Health Alliance | Sep 15, 2020 | News Release, Statements
The EU must hold pharma polluters to account to curb growing threat of antibiotic resistanceThe COVID-19 crisis has clearly demonstrated the borderless nature of deadly pathogens that can spread like wildfire across the globe. Antimicrobial resistance (AMR) is another...

by European Public Health Alliance | Jul 13, 2020 | News Release, Statements
The EU must ensure access to affordable and quality medicines in Europe whilst guaranteeing everyone’s right to a healthy and sustainable environment. Human medicine is not an ordinary commodity – public interest and public health should prevail as leading...